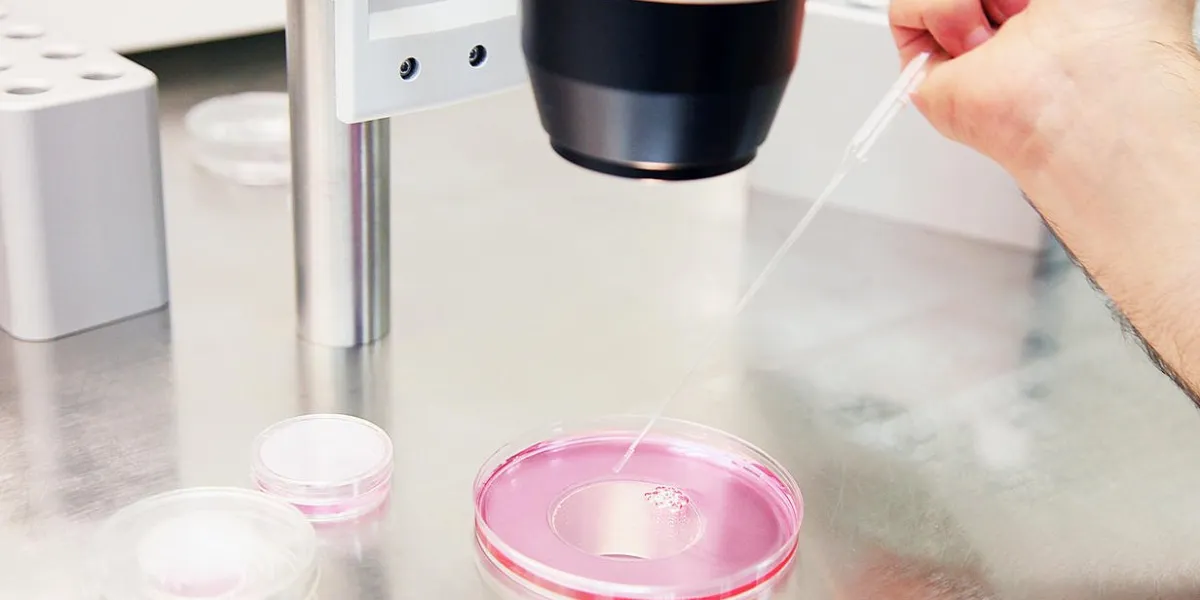
human egg analysis

Un bébé a été conçu à partir de 3 géniteurs en Grèce
En Grèce, le 9 avril 2019, un petit garçon est né. Un bébé de 2,9 kilos, en parfaite santé. Sa particularité ? Etre issu de trois géniteurs. Comment ? Grâce à une technique récente, appelée remplacement mitochondrial.
Remplacement mitochondrial ou FIV à 3 parents : en quoi ça consiste ?
Aussi connue sous le nom de fécondation in vitro (FIV) à 3 parents, cette méthode consiste à prélever l'ovule de la mère et à l'introduire dans celui de la donneuse, ainsi que le spermatozoïde du père en vue d'une fécondation en dehors de l'utérus.
Autorisée au Royaume-Uni en 2018, cette nouvelle forme de FIV s'adresse aux personnes souffrant d'une maladie mitochondriale : ces pathologies affectent les mitochondries, des organites qui créent l'énergie nécessaire au bon fonctionnement des cellules et qui contiennent de l'ADN, et sont ainsi potentiellement mortelles. La FIV à 3 parents permet donc de remplacer les mitochondries défaillantes par des mitochondries saines, afin de ne pas exposer le futur enfant, qui aura un peu de patrimoine génétique de chaque géniteur, à ces maladies.
Des indications bientôt élargies ?
Mais certains médecins voient également en cette technique un moyen d'augmenter les chances de réussite des FIV pour les femmes souffrant d'infertilité, les FIV classiques ayant un taux de réussite d'environ 26%. C'est pourquoi elle a été testée sur cette femme de 32 ans, qui a subi quatre cycles de FIV infructueux.
"Le droit inaliénable pour une femme de devenir mère à partir de son propre matériel génétique est enfin devenu une réalité, affirme le docteur Panagiotis Psathas, président de l'Institut de la Vie à Athènes. Nous sommes très fiers d'annoncer cette innovation internationale dans la procréation assistée, et nous sommes maintenant dans une position où il est possible pour les femmes ayant subi plusieurs échecs de FIV ou celles souffrant de rares maladies génétiques mitochondriales d'avoir un enfant en bonne santé."
FIV à 3 parents et infertilité : des questions éthiques
Alors que 24 autres femmes participeraient à cet essai et que huit embryons seraient déjà prêts à être implantés, d'autres médecins semblent moins emballés par l'élargissement de l'indication de la FIV à 3 parents. D'abord pour des questions d'éthique, cette technique impliquant la naissance de bébés génétiquement modifiés, et la fertilité et la prévention de la maladie étant, selon eux, "deux applications moralement très différentes".
Ensuite, parce que les risques d'une telle pratique n'ont pas encore été complètement identifiés : "s'ils peuvent être considérés comme acceptables dans le cas de la prévention des maladies mitochondriales, ce n'est pas le cas dans cette situation, argue le Dr Tim Child, interviewé par la BBC. La patiente aurait peut-être pu concevoir après une cinquième tentative de FIV standard."
Afficher les sources de cet article
"‘Three-person’ baby boy born in Greece". BBC. 11 avril 2019.
"FIV 3 parents". Etats généraux de la bioéthique.
"Chances de réussite d'une FIV". Guide de l'infertilité.